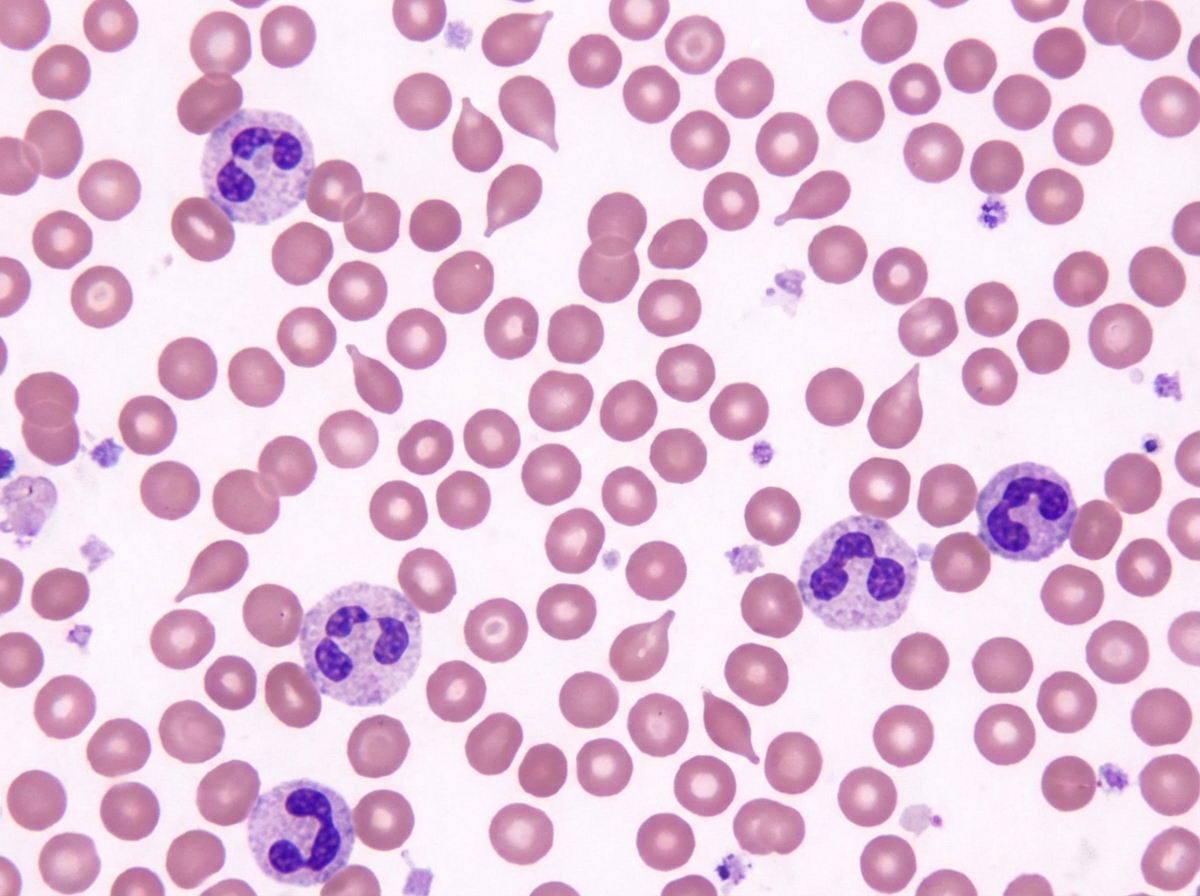
Image for question 33
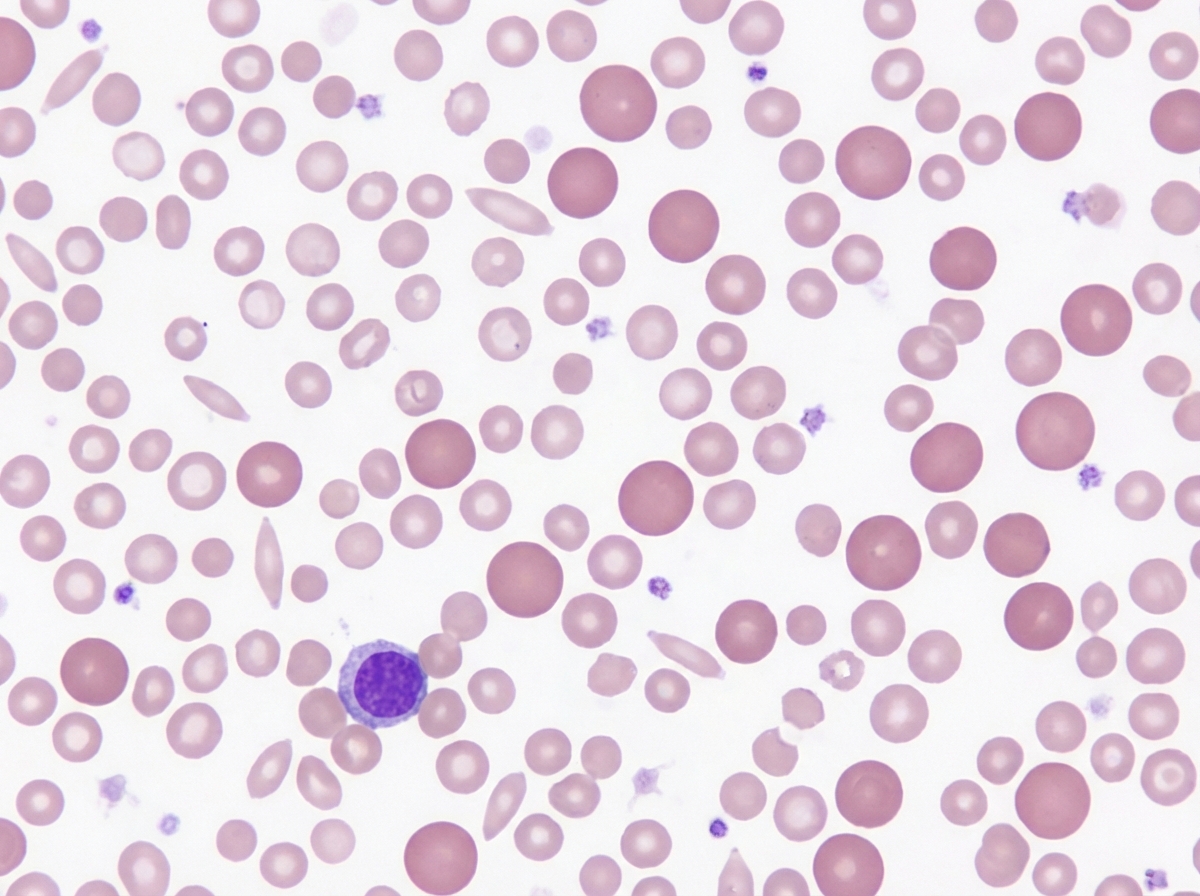
Image for question 34

All are true about the slide shown except:

A 45-year-old female has complaints of painless cervical lymphadenopathy with fever and weight loss. A lymph node biopsy was performed. All of the following statements are true regarding this condition except:

Which of the following is seen in the peripheral smear?
Spot the diagnosis.
A 6-year-old girl presents with bilateral cervical lymphadenopathy and fever for 3 weeks, night sweats and weight loss. Photomicrograph of lymph node biopsy is given. Diagnosis is:

A 12-year-old boy presents with bilateral cervical lymphadenopathy for the last 2 years. Biopsy from the lymph node shows the following picture. Which of the following is the correct set of diagnosis, etiology and the cell described?

A 35-year-old presented with fever. On examination he had enlarged and ulcerated tonsils. Since peripheral smear shows lymphocytosis, monospot test was done which is negative. Tonsillectomy was done and stained section is shown below. Large cells mixed with lymphocytes are seen. The cells are positive for CD20, EBVLMP-1, MUM1, CD 79a and CD 15 negative. The background cells are positive for CD3. Diagnosis is: (AIIMS May 2017)

A 70-year-old man presents with history of intractable diarrhea. His bone marrow and kidney biopsy are shown below. Which of the following is the most appropriate diagnosis?

Which of the following hematological condition is shown below?

Explanation: ***ABVD chemotherapy*** - ABVD (Adriamycin, Bleomycin, Vinblastine, Dacarbazine) is the standard chemotherapy regimen for **Hodgkin lymphoma**, not Burkitt lymphoma. - Burkitt lymphoma is typically treated with intensive, short-course chemotherapy regimens, often including high-dose methotrexate, cyclophosphamide, and cytarabine [3]. *Occurs due to c-Myc gene activation* - **Burkitt lymphoma** is characterized by translocations involving the **c-Myc oncogene**, most commonly t(8;14) [1]. - This translocation leads to the overexpression of the c-Myc protein, promoting uncontrolled cell proliferation [1]. *Non-Hodgkin's lymphoma* - Burkitt lymphoma is a highly aggressive type of **B-cell non-Hodgkin lymphoma (NHL)** [3]. - It is one of the fastest-growing human tumors. *Burkitt lymphoma* - The "starry sky" appearance on a biopsy, with numerous tingible body macrophages amidst a monotonous population of small, non-cleaved lymphocytes, is a classic histological feature of **Burkitt lymphoma** [2]. - This appearance is due to the rapid proliferation of lymphoma cells and the presence of macrophages phagocytosing apoptotic tumor cells [2]. **References:** [1] Kumar V, Abbas AK, et al.. Robbins and Cotran Pathologic Basis of Disease. 9th ed. Neoplasia, pp. 324-325. [2] Kumar V, Abbas AK, et al.. Robbins and Cotran Pathologic Basis of Disease. 9th ed. Diseases of White Blood Cells, Lymph Nodes, Spleen, and Thymus, p. 606. [3] Kumar V, Abbas AK, et al.. Robbins and Cotran Pathologic Basis of Disease. 9th ed. Diseases of White Blood Cells, Lymph Nodes, Spleen, and Thymus, pp. 605-606.
Explanation: ***CD15+, CD20+ and CD30+*** - Hodgkin's lymphoma Reed-Sternberg cells are typically **CD15+ and CD30+**, but **CD20−** (negative). - The claim that RS cells are CD20+ is **incorrect** — CD20 positivity would instead suggest a B-cell non-Hodgkin lymphoma. - This makes the statement FALSE, confirming it as the correct exception. *5-year survival rate is high* - Hodgkin's lymphoma generally has a **high 5-year survival rate** (>85% in early stages) due to its excellent responsiveness to chemotherapy (ABVD) and radiation therapy. - This statement is **TRUE**, so it is not the exception. *Reed-Sternberg cells are pathognomonic for Hodgkin's lymphoma* - Classic **Reed-Sternberg cells** (large binucleated giant cells with prominent "owl-eye" nucleoli) are the hallmark finding of Hodgkin's lymphoma and are considered **pathognomonic** in the appropriate clinical context. - This statement is **TRUE**, so it is not the exception. *LP must be done to rule out meningeal involvement* - **Lumbar puncture (LP)** is NOT routinely performed in Hodgkin's lymphoma; it is reserved for aggressive non-Hodgkin lymphomas (e.g., diffuse large B-cell lymphoma) or when neurological symptoms are present. - While this statement is also false, **Option A (CD20+) is more definitively incorrect** and is the standard teaching point. *EBV association is seen in some cases* - **Epstein-Barr Virus (EBV)** is associated with approximately **30–40% of classical Hodgkin's lymphoma cases**, particularly the mixed cellularity subtype. - EBV-encoded RNA (EBER) can be detected in Reed-Sternberg cells in these cases. - This statement is **TRUE**, so it is not the exception. **References:** [1] Kumar V, Abbas AK, et al. Robbins and Cotran Pathologic Basis of Disease. 9th ed. Diseases of White Blood Cells, Lymph Nodes, Spleen, and Thymus, pp. 614–618. [2] Cross SS. Underwood's Pathology: A Clinical Approach. 6th ed. pp. 559–560.
Explanation: ***Band cells, tear drop cells, hyposegmented neutrophils*** - **Band cells** and **hyposegmented neutrophils** (Pelger-Huët anomaly) are characteristic findings in **myelodysplastic syndromes (MDS)**, which often present with peripheral smear abnormalities. - **Tear drop cells** (dacryocytes) are indicative of **extramedullary hematopoiesis** or **myelofibrosis**, conditions often associated with MDS or other myeloproliferative neoplasms [1]. *Smudge cells, tear drop cells, hyposegmented neutrophils* - **Smudge cells** are characteristic of **chronic lymphocytic leukemia (CLL)**, not typically seen in conditions presenting with hyposegmented neutrophils or tear drop cells as primary features. - While tear drop cells and hyposegmented neutrophils can be seen in various conditions, their combination with smudge cells is not a typical diagnostic triad. *Lacunar cells, tear drop cells, atypical lymphocytes* - **Lacunar cells** are a specific type of **Reed-Sternberg cell variant** seen in **nodular sclerosis Hodgkin lymphoma**, which is a lymphoproliferative disorder, not typically associated with tear drop cells or hyposegmented neutrophils. - **Atypical lymphocytes** are seen in viral infections like **infectious mononucleosis** or some lymphomas, not usually alongside lacunar cells and tear drop cells in a single peripheral smear. *Reed-Sternberg cells, tear drop cells, atypical monocytes* - **Reed-Sternberg cells** are pathognomonic for **Hodgkin lymphoma** and are found in lymph node biopsies, not typically in the peripheral blood smear. - **Atypical monocytes** can be seen in various conditions, but their presence with Reed-Sternberg cells and tear drop cells does not form a coherent diagnostic picture for a peripheral smear. **References:** [1] Kumar V, Abbas AK, et al.. Robbins and Cotran Pathologic Basis of Disease. 9th ed. Diseases of White Blood Cells, Lymph Nodes, Spleen, and Thymus, pp. 628-629.
Explanation: ***Dimorphic anemia*** - This term refers to the coexistence of two types of anemia, typically **iron deficiency anemia** (microcytic, hypochromic) [2] and **megaloblastic anemia** (macrocytic) [1]. - This can occur when there is a deficiency of both **iron** and **vitamin B12** or **folate** [1][2]. *Thalassemia* - Thalassemia is a **genetic disorder** characterized by reduced or absent synthesis of globin chains, leading to **microcytic, hypochromic anemia** [3]. - It is not typically associated with the presence of two distinct red cell populations (microcytic and macrocytic) simultaneously. *Megaloblastic anemia* - Megaloblastic anemia is caused by impaired DNA synthesis, most commonly due to **vitamin B12** or **folate deficiency**, leading to **macrocytic red blood cells** [1]. - While it explains the macrocytic component, it does not account for the presence of a microcytic, hypochromic population. *G6PD deficiency* - G6PD deficiency is an **X-linked genetic disorder** that causes **hemolytic anemia** due to oxidative stress, often triggered by certain drugs, foods, or infections. - It typically presents with **normocytic or macrocytic anemia** during hemolytic episodes, and is not characterized by a dimorphic picture of microcytic and macrocytic cells. **References:** [1] Cross SS. Underwood's Pathology: A Clinical Approach. 6th ed. Common Clinical Problems From Blood And Bone Marrow Disease, pp. 593-594. [2] Cross SS. Underwood's Pathology: A Clinical Approach. 6th ed. Common Clinical Problems From Blood And Bone Marrow Disease, pp. 590-591. [3] Cross SS. Underwood's Pathology: A Clinical Approach. 6th ed. Common Clinical Problems From Blood And Bone Marrow Disease, pp. 587-588.
Explanation: ***Hodgkin's lymphoma*** - The clinical presentation of **fever**, **night sweats**, and **weight loss** (B symptoms) along with **lymphadenopathy** is classic for Hodgkin's lymphoma [2][3]. - A lymph node biopsy showing **Reed-Sternberg cells** (often implied by "photomicrograph of lymph node biopsy" in this context) is diagnostic for Hodgkin's lymphoma [1][2]. *Non-Hodgkin's lymphoma* - While Non-Hodgkin's lymphoma can present with lymphadenopathy and B symptoms, its histological features are diverse and do not typically involve **Reed-Sternberg cells** [2]. - It often has a more widespread presentation at diagnosis, including extranodal involvement, which is not specified here [2]. *Chronic lymphocytic leukemia* - CLL primarily affects **older adults** and is characterized by a proliferation of mature B lymphocytes, often presenting with **lymphocytosis** in peripheral blood. - While it can cause lymphadenopathy, the presence of B symptoms in a 6-year-old girl makes it less likely, and the characteristic biopsy findings would be different. *Acute lymphocytic leukemia* - ALL is common in **children** and presents with symptoms related to bone marrow failure (e.g., **anemia**, **thrombocytopenia**, **infections**) due to the proliferation of immature lymphoblasts. - While lymphadenopathy can occur, the primary presentation is usually not isolated to lymph nodes with prominent B symptoms without other signs of bone marrow involvement. **References:** [1] Kumar V, Abbas AK, et al.. Robbins and Cotran Pathologic Basis of Disease. 9th ed. Diseases of White Blood Cells, Lymph Nodes, Spleen, and Thymus, p. 616. [2] Kumar V, Abbas AK, et al.. Robbins and Cotran Pathologic Basis of Disease. 9th ed. Diseases of White Blood Cells, Lymph Nodes, Spleen, and Thymus, pp. 614-616. [3] Kumar V, Abbas AK, et al.. Robbins and Cotran Pathologic Basis of Disease. 9th ed. Diseases of White Blood Cells, Lymph Nodes, Spleen, and Thymus, pp. 616-618.
Explanation: ***Hodgkin's lymphoma; Epstein-Barr virus and Reed-Sternberg cells*** - The presence of **bilateral cervical lymphadenopathy** for two years, especially in a young boy, is highly suggestive of a lymphoproliferative disorder like Hodgkin's lymphoma [1]. - **Reed-Sternberg cells** are the hallmark of Hodgkin's lymphoma [1], and **Epstein-Barr virus (EBV)** is a known etiological factor, particularly in classical Hodgkin's lymphoma [1]. *Tuberculosis, Mycobacterium and Tiny granuloma* - While **tuberculosis** can cause chronic lymphadenopathy, the biopsy description (implied to show specific cells) does not align with the typical **granulomatous inflammation** and **caseous necrosis** seen in TB. - **Tiny granulomas** are not the characteristic finding for diagnosing tuberculosis in lymph nodes; larger, well-formed granulomas are more common. *Hodgkin's lymphoma; Epstein-Barr virus and orphan annie eye nucleus* - Although **Hodgkin's lymphoma** and **Epstein-Barr virus** are correct [1], the term **"orphan annie eye nucleus"** refers to the characteristic nuclear appearance of **papillary thyroid carcinoma**, not Reed-Sternberg cells. - Reed-Sternberg cells have a distinct **binucleated or multinucleated appearance** with prominent eosinophilic nucleoli [1], often described as "owl's eye" appearance, not "orphan annie eye." *Non-Hodgkin's lymphoma; HIV and popcorn cell* - **Non-Hodgkin's lymphoma (NHL)** can present with lymphadenopathy, and **HIV** is a risk factor for certain types of NHL. - However, **"popcorn cells"** (also known as L&H cells or lymphocytic and histiocytic cells) are characteristic of **nodular lymphocyte-predominant Hodgkin's lymphoma (NLPHL)** [1], a specific subtype of Hodgkin's lymphoma, not typically associated with other NHLs in this context. **References:** [1] Kumar V, Abbas AK, et al.. Robbins and Cotran Pathologic Basis of Disease. 9th ed. Diseases of White Blood Cells, Lymph Nodes, Spleen, and Thymus, pp. 614-618.
Explanation: ***EBV positive- mucocutaneous ulcer*** - The presence of **large B-cells (CD20+, CD79a+, MUM1+)** that are **EBV-positive (EBVLMP-1+)** in an ulcerated tonsil, with a **CD15 negative** profile and a background of **CD3+ T-cells**, in a patient with a negative monospot test, is characteristic of **EBV-positive mucocutaneous ulcer**. - This condition is a **polymorphic lymphoproliferative disorder** that typically presents as a localized ulcer and is associated with **immunosuppression** or **immunosenescence**, often resolving with reduced immunosuppression. *Infectious mononucleosis* - While also caused by **EBV** and presenting with **fever** and **enlarged/ulcerated tonsils**, infectious mononucleosis typically has a **positive monospot test** and shows reactive **T-cell lymphocytosis** on peripheral smear [1]. - The large cells in infectious mononucleosis are primarily **atypical T-lymphocytes**, not large B-cells with the described immunophenotype [1]. *Hodgkin lymphoma* - Hodgkin lymphoma is characterized by **Reed-Sternberg cells** and their variants, which are typically **CD15+** and **CD30+**, and **CD20 negative** (or weakly positive), which contradicts the given immunophenotype (CD20+, CD15-) [2][3]. - While some forms of Hodgkin lymphoma are EBV-associated [4], the overall immunophenotype and the description of "large cells mixed with lymphocytes" rather than classic Reed-Sternberg cells make this less likely [2]. *EBV positive- DLBCL* - **EBV-positive diffuse large B-cell lymphoma (DLBCL)** typically presents as a **mass-forming lesion** and is a more aggressive lymphoma. - While it shares the **EBV positivity** and **B-cell immunophenotype (CD20+, CD79a+, MUM1+)**, the clinical presentation as a localized ulcer in a potentially immunocompromised setting, along with the specific mention of "mucocutaneous ulcer," points more towards the distinct entity of EBV-positive mucocutaneous ulcer, which is often a more indolent, self-limiting process. **References:** [1] Kumar V, Abbas AK, et al.. Robbins and Cotran Pathologic Basis of Disease. 9th ed. Infectious Diseases, pp. 369-370. [2] Kumar V, Abbas AK, et al.. Robbins and Cotran Pathologic Basis of Disease. 9th ed. Diseases of White Blood Cells, Lymph Nodes, Spleen, and Thymus, pp. 614-616. [3] Cross SS. Underwood's Pathology: A Clinical Approach. 6th ed. Common Clinical Problems From Diseases Of The Urinary And Male Genital Tracts, pp. 556-557. [4] Kumar V, Abbas AK, et al.. Robbins and Cotran Pathologic Basis of Disease. 9th ed. Diseases of White Blood Cells, Lymph Nodes, Spleen, and Thymus, pp. 616-618.
Explanation: ***Multiple myeloma*** - The combination of intractable diarrhea, bone marrow findings (likely showing **plasma cell proliferation**), and kidney biopsy findings (suggesting **cast nephropathy** or **amyloidosis**) is highly indicative of multiple myeloma [1][3][4]. - **Monoclonal immunoglobulin light chains** produced by plasma cells can cause renal damage and gastrointestinal symptoms like diarrhea [1][2][4]. *Leishmaniasis* - Characterized by **fever**, **splenomegaly**, and **pancytopenia**, with parasites found in macrophages. - While it can affect the bone marrow, it does not typically cause the specific kidney pathology or intractable diarrhea seen in this context. *Lymphoma* - Involves the proliferation of **lymphocytes** and can present with systemic symptoms like fever, weight loss, and lymphadenopathy. - While it can infiltrate the bone marrow and kidneys, it typically does not cause the specific renal casts or amyloid deposition seen in multiple myeloma, nor is intractable diarrhea a primary feature [5]. *Urate nephropathy* - Caused by the deposition of **uric acid crystals** in the renal tubules, leading to acute kidney injury, often in the context of tumor lysis syndrome or gout. - It does not explain the intractable diarrhea or the primary bone marrow pathology of plasma cell proliferation. **References:** [1] Cross SS. Underwood's Pathology: A Clinical Approach. 6th ed. Common Clinical Problems From Blood And Bone Marrow Disease, pp. 616-617. [2] Kumar V, Abbas AK, et al.. Robbins and Cotran Pathologic Basis of Disease. 9th ed. Diseases of White Blood Cells, Lymph Nodes, Spleen, and Thymus, pp. 607-608. [3] Cross SS. Underwood's Pathology: A Clinical Approach. 6th ed. Common Clinical Problems From Blood And Bone Marrow Disease, pp. 617-618. [4] Cross SS. Underwood's Pathology: A Clinical Approach. 6th ed. Common Clinical Problems From Blood And Bone Marrow Disease, pp. 618-619. [5] Kumar V, Abbas AK, et al.. Robbins and Cotran Pathologic Basis of Disease. 9th ed. Diseases of White Blood Cells, Lymph Nodes, Spleen, and Thymus, pp. 606-607.
Explanation: ***Megaloblastic anemia*** - The image likely displays **hypersegmented neutrophils** and **macrocytic red blood cells**, which are characteristic features of **megaloblastic anemia** [1]. - This condition results from impaired DNA synthesis, often due to **vitamin B12** or **folate deficiency**. *Multiple myeloma* - This condition is characterized by the proliferation of **plasma cells** in the bone marrow, leading to **rouleaux formation** of red blood cells and **punched-out lesions** in bones [2]. - While rouleaux can be seen, the primary features of megaloblastic anemia (hypersegmented neutrophils, macro-ovalocytes) are distinct. *CML* - **Chronic Myeloid Leukemia (CML)** is a myeloproliferative neoplasm characterized by the presence of the **Philadelphia chromosome** (BCR-ABL fusion gene) [3]. - Peripheral blood smears typically show a **leukocytosis** with a full spectrum of myeloid maturation, including increased **basophils** and **eosinophils**, which are not the defining features of the image. *Metastasis* - **Metastasis** refers to the spread of cancer cells from a primary tumor to distant sites, often involving the bone marrow. - While bone marrow involvement can lead to various hematological abnormalities, the specific features of **hypersegmented neutrophils** and **macrocytic red blood cells** are not directly indicative of metastasis but rather of a primary hematological disorder like megaloblastic anemia. **References:** [1] Cross SS. Underwood's Pathology: A Clinical Approach. 6th ed. Common Clinical Problems From Blood And Bone Marrow Disease, pp. 613-614. [2] Kumar V, Abbas AK, et al.. Robbins and Cotran Pathologic Basis of Disease. 9th ed. Diseases of White Blood Cells, Lymph Nodes, Spleen, and Thymus, pp. 606-607. [3] Kumar V, Abbas AK, et al.. Robbins and Cotran Pathologic Basis of Disease. 9th ed. Diseases of White Blood Cells, Lymph Nodes, Spleen, and Thymus, pp. 624-625.
Red blood cell disorders
Practice Questions
White blood cell disorders
Practice Questions
Platelet disorders
Practice Questions
Coagulation disorders
Practice Questions
Acute leukemias
Practice Questions
Chronic leukemias
Practice Questions
Myeloproliferative neoplasms
Practice Questions
Myelodysplastic syndromes
Practice Questions
Hodgkin lymphoma
Practice Questions
Non-Hodgkin lymphomas
Practice Questions
Plasma cell disorders
Practice Questions
Bone marrow failure syndromes
Practice Questions
Splenic pathology
Practice Questions
Get full access to all questions, explanations, and performance tracking.
Start For Free